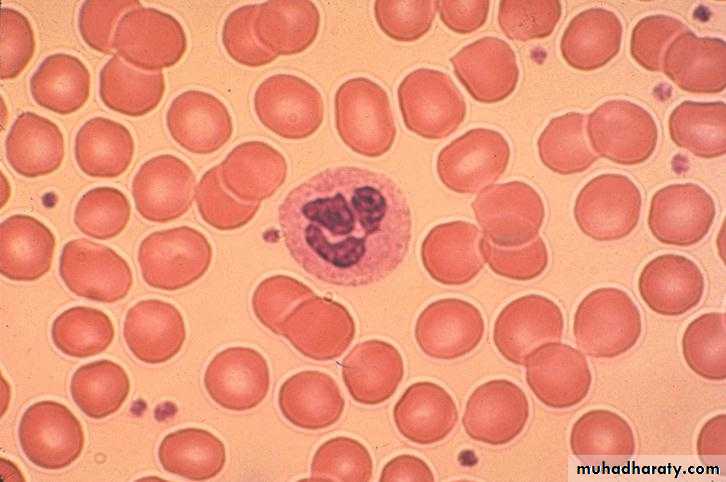
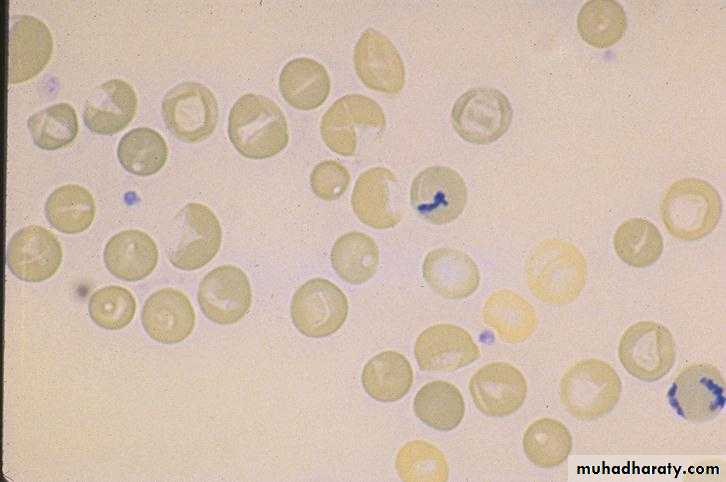
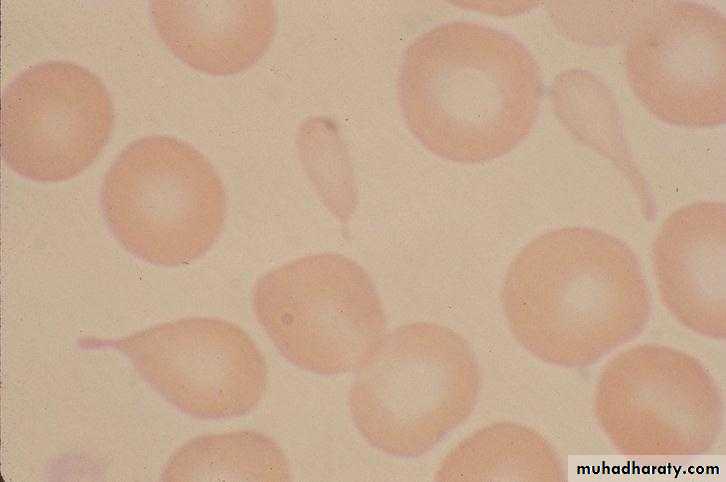
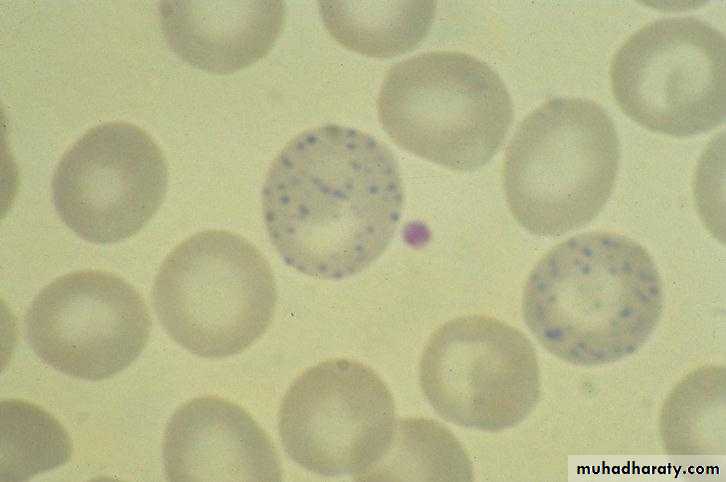
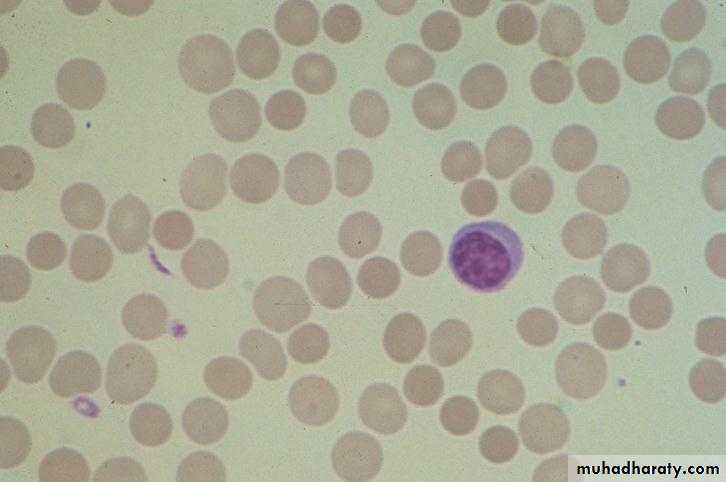
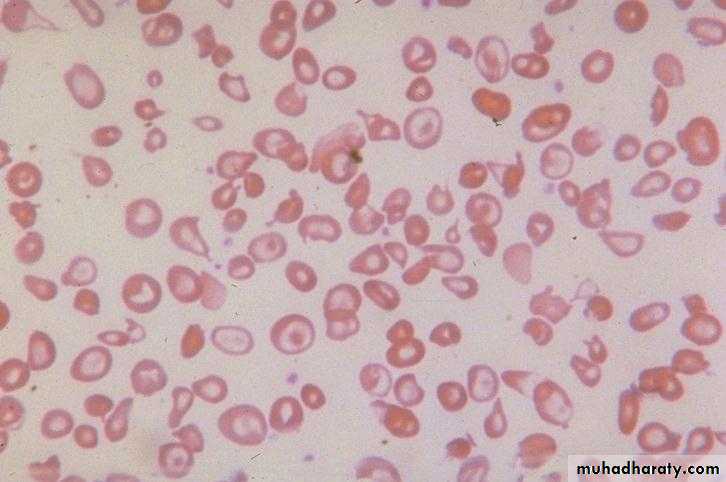
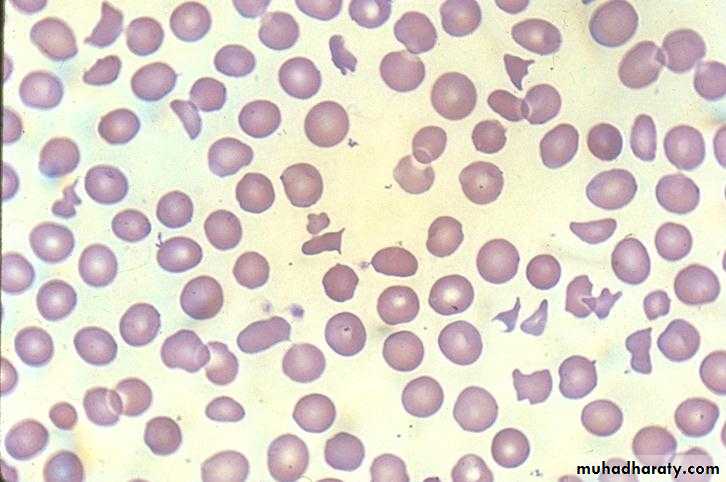
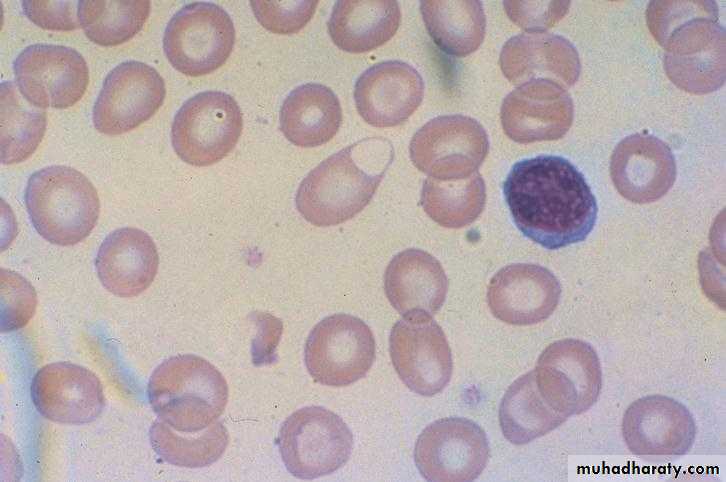

Red Blood Cells Disorders
Ali M. JawadProfessor of Haematology
Department of Medicine
College of Medicine - University of Baghdad
2015
Objectives
• By the end of these lectures,the student will be able to:• Describe briefly the physiology of normal haematopoiesis.
• Define the term anaemia, its pathophysiology and diagnostic approach.
• List the common causes , clinical features and diagnosis of iron-deficiency anaemia. State how iron deficiency anaemia may be treated.
• Define the terms megaloblastic anaemia and anaemia of chronic diseases. In each case discuss their causes, consequences and management.
• Define the terms aplastic anaemia and myelodysplastic syndrome. In each case an over view of clinical features, diagnosis and treatment is outlined.
Hematopoiesis
Hierarchical model of lymphohematopoiesis. RBC-red blood cell; NK cell-natural killer cellErythroid maturation sequence: As proliferation parameters (i.e., rates of DNA and RNA synthesis) and cell size decrease, accumulation of erythroid-specific proteins (i.e., heme and globin) increases, and the cells adapt their characteristic morphology.
*Hematopoietic Cytokines
• 1- Stem cell Factor.• 2- IL-2, IL-3, IL-4, IL-5, IL-6, IL-7, IL-9.
• 3- G-CSF.
• 4-GM-CSF.
• 5-Erythropoietin.
• 6-Thrombopoietin.
• 7-Others
• *Glycoproteins that act on cell surface receptors .Initiate complex Second messenger and transcriptional and post-transcriptional regulation.
Case Presentation
A 40 year old lady presented with easy fatigability, palpitation on exertion,postural dizziness and increasing pallor of one month duration.
Her systemic review revealed menorrhagia and mild weight loss.
The clinical examination revealed normal vital signs, moderate pallor, and koilonychia.
What is your provisional diagnosis?
Anemia
• DEFINITION:Reduction in the number of erythrocytes, or hemoglobin concentration ,or packed cell volume (PCV) value below lower normal limit for age and sex.
*Anemia is not a disease, it is rather a manifestation of different diseases.
NORMAL VALUES FOR RED BLOOD CELL MEASUREMENTS(INDICES)
• NORMAL RANGE (APPROXIMATE)• UNITS
• MEASUREMENT
• Adult Males: 13 – 18Adult Females: 12 – 16
• g/dL
• Hemoglobin
• Adult Males: 40 – 54Adult Females: 37 – 47
• %
• Hematocrit (PCV)
• Males: 4.5 – 6Females: 4 – 5.4
• X 1012/ L
• Red blood cell (RBC) count
• 78 – 98
• fL
• Mean cell volume (MCV)
• 30 – 34
• g/dL
• Mean cell hemoglobin concentration (MCHC(
• 30 – 36
• pg
• Mean cell hemoglobin (MCH(
• 40000 - 100000
• / mL of blood
• Reticulocyte count (absolute number)
• 0.5 – 1.5
• % of RBC
• Reticulocyte percentage
Normal Red Blood Cell
• #Average lifespan is approximately 120 days.
• #It is a non-nucleated, non-dividing cell in which more than 90% of the protein content is the oxygen-carrying molecule, hemoglobin.
• #The responsibility is to deliver oxygen to the tissues of the body.Thus, the primary consequence of anemia is tissue hypoxia.
• #Erythropoiesis is driven by erythropoietin secreted by the kidneys in response to hypoxia.
Etiology Of Anemia
1- Decreased Production of RBC/Hemoglobin (Hypoproliferative Anemia).2- Increased Destruction of RBC(Hemolysis).
3- Blood Loss.4- Sequestration.
Effects of AnemiaPhysiological: due to tissue hypoxia.
1-Increased 2,3 DPG in RBC(helps to deliver more oxygen to tissues).
2-Increased Cardiac Output (heart rate and stroke volume).
3-Redistribution of Blood Flow to vital organs.
Clinical:
1-Pallor of the skin and mucous membranes.
2-Easy Fatigability due to muscle hypoxia.
3-Cardiovascular: dizziness, SOB, worsening of IHD and HF.
4-Loss of Concentration due to brain hypoxia.
5-Other effects.
Approach To Anemia
• 1. History• Bleeding source specially GI and genital.
• Drugs e.g. Aspirin, NSAIDs,sulfa drugs,chloramphenicol etc...
• Family history of anemia,blood transfusion and ethnic background.
• Diet.
• Chronic diarrhoea.
• Recent pregnancy.
• Weight loss and anorexia.
• Symptoms
• General: fatigue, malaise, weakness.
• CVS: palpitations, syncope, dyspnea.
• Neurological: headache, vertigo, tinnitus, numbness
Approach To Anemia
• 2. Physical Examination
• CVS: tachycardia, systolic flow murmur, wide pulse pressure,evidence of CHF.
• Pallor: mucous membranes, conjunctiva (Hb < 9g/dl), skin creases (Hb < 7g/dl).
• Splenomegaly; seen in different hematological and non hematological conditions.
• Lymphadenopathy,bleeding spots.
• Rectal (occult blood).
• Others
• • Koilonychia (spoon-shaped nails)and Glossitis as in iron deficiency anemia,
• • Neurological findings as in pernicious anemia and vitamin B6 deficiency.
• • Jaundice as in hemolytic anemia
• 3. Complete Blood Counts and Blood Film
• Hemoglobin level, WBC count and differential, platelet count, blood film morphology, reticulocyte count and percentage, RBC indices.
CLINICAL APPROACH TO ANEMIA (continue)
• High Reticulocytes• Low or Normal Reticulocytes
• • Treated iron deficiency
• • Thalassemia major
• • Iron deficiency
• • Thalassemia minor
• • Sideroblastic anemia
• • Lead poisoning
• • Chronic disease
• Hypochromic Microcytic (mean red cell volume MCV < 78)
• • Hemolytic anemia
• • Post hemorrhagic anemia
• • Chronic disease : Liver disease, Uremia ,• Endocrine disorders (hypo/hyperthyroid, addison’s),• Connective tissue diseases.
• • Primary bone marrow abnormalities: Myelodysplasia, •Marrow Infiltration (leukemia, myeloma, infection) , Myelofibrosis , Aplasia
• Normochromic Normocytic (MCV 78– 98 )
• • Treated vit B12 or folate deficiency
• •Megaloblastic :low vit B12 ,low Folate
• • Drugs (MTX, cyclophosphamide ,arsenic)
• •Macrocytic :• Hypothyroidism
• • Hypoplastic marrow, aplasia
• • Liver disease • Alcohol
• Macrocytic/Megaloblastic (MCV > 98 )
RED BLOOD CELL MORPHOLOGY AS A CLUE TO THE DIAGNOSIS OF ANEMIAS
• REPRESENTATIVE CAUSES OF ANEMIA
• RBC MORPHOLOGY
• Iron deficiency, anemia of chronic disease, thalassemia, and (rarely) lead poisoning, vitamin B6 deficiency, or hereditary sideroblastic anemias
• Microcytosis
• Polychromatophilia (reticulocytsis), vitamin B12 (cobalamin) or folate deficiency, myelodysplasia, use of drugs that inhibit DNA synthesis
• Macrocytosis
• Thalassemia, hemoglobins C, D, E, and S, liver disease, abetalipoproteinemia
• Target cells
• Autoimmune hemolytic anemia, alloimmune hemolysis, hereditary spherocytosis, some cases of Heinz body hemolytic anemias
• Microspherocytes
• Thrombotic thrombocytopenic purpura, disseminated intravascular coagulation, vasculitis, malignant hypertension, eclampsia, traumatic hemolysis due to prosthetic heart valve or damaged vascular graft, thermal injury (burns), post-splenectomy
• Schistocytes and fragmented RBCs
• Myelofibrosis, myelophthisis (bone marrow infiltration by neoplastic cells)
• Teardrop cells
• Sickle cells Hemoglobin SS, SC.
• Sickle cells
• Hemolysis, lead poisoning, thalassemia
• Basophilic stippling
• "Glucose-6-phosphate dehydrogenase deficiency, other oxidant-induced hemolysis, unstable hemoglobins
• Bite" cells or "blister"cells
Approach To Anemia(continue)
Other Investigations are guided by the clinical impression after the initial evaluation.
1-Iron Studies.
2-Measurment of vitamin B12 and Folate serum levels.
3-Bone Marrow Aspirate and Biopsy.
4-Coomb,s Test.
5-Osmotic Fragility test.
6-Hemoglobin Electrophoresis.
7-RBC enzyme studies.
8-Chromosomal studies,Molecular studies.
9-Other studies.
Normal Blood Film
•Reticulocytes
Tear Drop Cells
Basophilic Stippling
Sickle RBC
Spherocytes
Hypochromia and Target Cells
Fragmented RBC
Blister RBC
Bone marrow iron stores
SummaryAnemia is a manifestation of different diseases.
The anemia is either due to blood loss, decreased production of Hemoglobin and or RBCs ,increased RBC destruction or RBC sequestration.
The clinical manifestations are mainly due to tissue hypoxia and cardiovascular effects.
Proper initial evaluation needs a good history and physical examination along with proper CBP ,reticulocyte count,RBC indices and a good blood film.